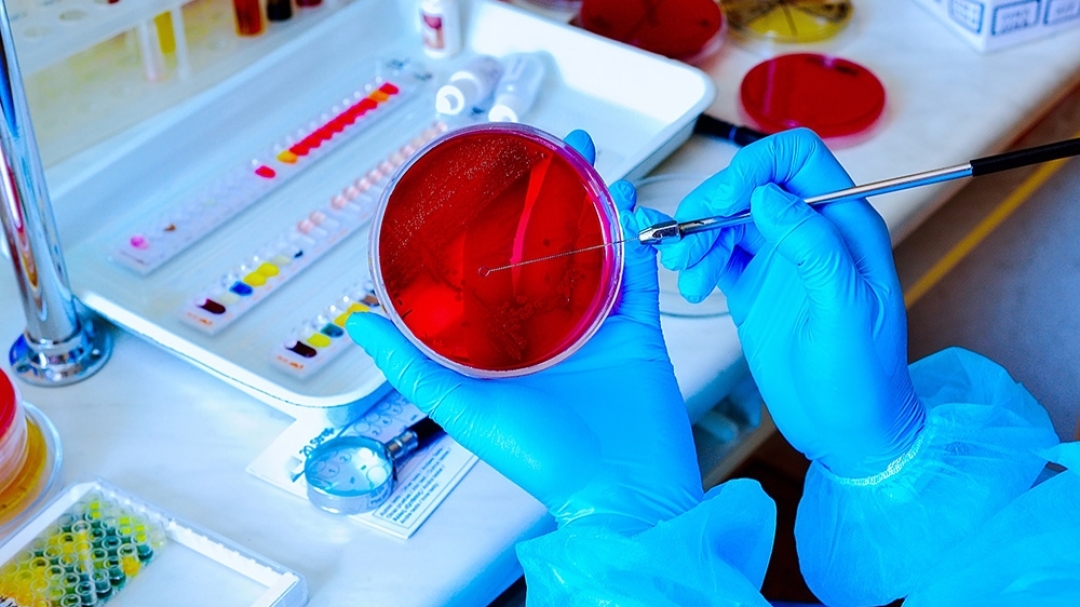

Critical Appraisal Blog
News and views on the world of critical appraisal skills training.
Filter
Showing 108 results for Bespoke Course

Research Skills Training for Clinical Microbiology Trainees
02nd Apr 2025 | Bespoke Course
In March 2025, we delivered a tailored training session for a group of Clinical Microbiology trainees, focused on building confidence in core research skills es...
Find out more
Full-Day Critical Appraisal Training in Dublin for Medical Specialists
18th Mar 2025 | Evidence-Based Training, Bespoke Course
In March 2025, we were pleased to deliver a full-day, in-person training session at the Ashling Hotel in Dublin, focused on critical appraisal and evidence-base...
Find out more
Leicester Marriot Hotel - Microbiology and Haematology Clinicians & Pharmacists
06th Mar 2024 | Bespoke Course
We were delighted to work with Microbiology and Haematology clinicians & pharmacists in Leicester. Delegates attended from across the Leicester hospitals. ...
Find out more
Geneva – Medical Advisors & Medical Science Liaison Teams
15th Feb 2024 | Bespoke Course
We've been working with a pharmaceutical company to design a course to improve critical appraisal skills amongst MSLs. The one day event took place in Geneva. ...
Find out more
Critical appraisal requirements for RCTs & RWE – Fundamental & Advanced Courses
27th Sep 2023 | Bespoke Course, Journal Club
We were delighted to teach critical appraisal skills medical experts from a pharmaceutical organisation. The course was aimed at upskilling teams on how to appr...
Find out more
Manchester – Medical Advisors & Medical Science Liaison Teams
13th Jun 2023 | Bespoke Course
We've been working with a pharmaceutical company to design a course to improve critical appraisal skills amongst MSLs. The one day event took place in Mancheste...
Find out more
Rare Diseases and the relevance of Real World Evidence (RWE)
23rd May 2023 | Bespoke Course
We presented at a bespoke event for MSLs across Europe on rare diseases and real world evidence. We looked at the importance of generating robust RWE to support...
Find out more
Medical Microbiology meeting
05th May 2023 | Bespoke Course
We organised a tailor-made Live Virtual Classroom Course via WebEx for pharmaceutical medical colleagues. The session was tailor-made and covered the key topic...
Find out more
Rare Diseases and the relevance of Real World Evidence (RWE)
21st Apr 2023 | Bespoke Course
We presented at a bespoke event for MSLs across the Midlands on rare diseases and real world evidence. A mixture of RWE clinical papers for the practical appli...
Find out more
Windsor: Improving critical appraisal skills for future Consultants
07th Apr 2023 | Bespoke Course
Windsor was the venue for a training course this week for a pharmaceutical company. The training was called ‘Pitfalls in Medical Statistics in Clinical Trials’....
Find out more